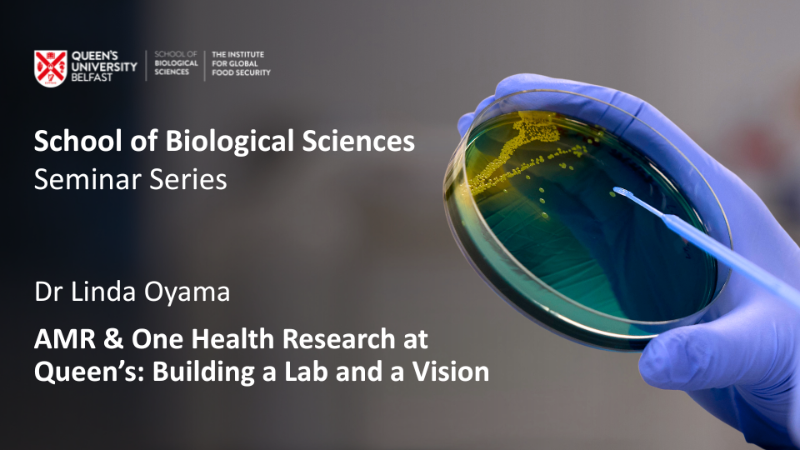

Join us for the next instalment in our school seminar series, ‘AMR & One Health Research at Queen’s: Building a Lab and a Vision,’ presented by Dr Linda Oyama
- Date(s)
- October 29, 2025
- Location
- Lecture Theatre, School of Biological Sciences
- Time
- 13:00 - 14:00
Dr Linda Boniface Oyama is a Senior Lecturer in Microbiomics, Antimicrobial Resistance, and One Health at Queen’s University Belfast. She founded the AMR & One Health Lab in 2022, and in just three years has grown it into a thriving group of doctoral researchers, postdocs, and collaborators working across human, animal, and environmental health. As both a researcher and mentor, Linda is passionate about creating a supportive environment for early-career researchers, while building ambitious interdisciplinary projects that push forward AMR solutions. Her perspective combines the excitement of new discoveries with the honest lessons of starting out as a new PI, from shaping a research vision to the day-to-day realities of leading a young lab.
Abstract:
Antimicrobial resistance (AMR) remains one of the most pressing global health challenges, requiring innovative solutions that span the human, animal, and environmental interface. In this seminar, I will introduce the research of the AMR & One Health Lab at Queen’s University Belfast, highlighting our work over the past three years to advance understanding of microbiomes, antimicrobial peptides, and antimicrobial stewardship. Alongside sharing recent scientific progress, I will also reflect on the journey of starting a new research group, the opportunities, challenges, and lessons learned in building a young team with a shared vision. The talk will provide both a scientific overview of our ongoing projects and a personal perspective on the realities of establishing and growing a research group in AMR and One Health.
- Department
- School of Biological Sciences
- Add to calendar